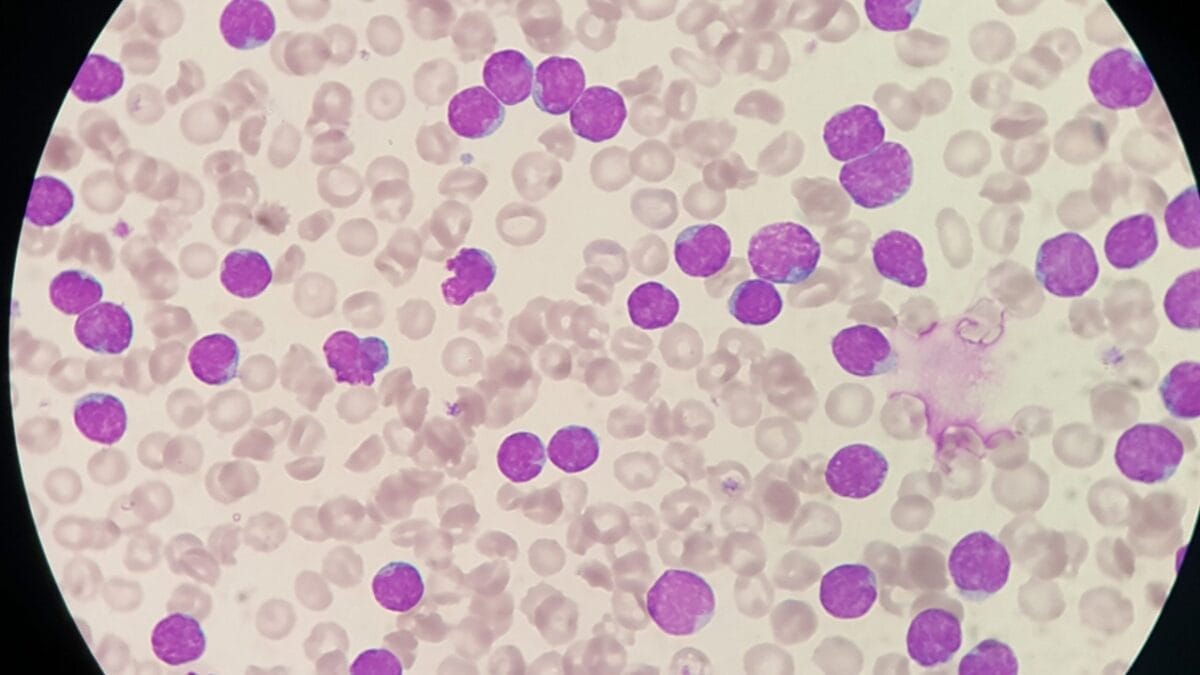
High White Blood Cell Counts in Dogs: 6 Probable Causes 4 High White Blood Cell Counts in Dogs: 6 Probable Causes - leukemia dog ss1883301037

As a pet owner, it’s essential to understand that a high white blood cell count, also known as leukocytosis, can be an indication of an underlying health issue in your furry friend1.
White blood cells are a crucial part of your dog’s immune system, responsible for fighting off infections and diseases. When their levels become elevated, it could signify that your pup’s body is battling something more serious.
We’ll look into six potential causes of high white blood cell counts in dogs, so you can better understand what might be going on with your beloved pet.
1. Infections

Infections, whether bacterial, viral, fungal, or parasitic, can trigger an increase in white blood cell production. This is because white blood cells are the body’s first line of defense against invading pathogens.
When an infection strikes, the bone marrow kicks into high gear, producing more white blood cells to fight off the intruders.
Common infections that may lead to leukocytosis in dogs include:
- Respiratory infections (kennel cough, pneumonia)
- Urinary tract infections
- Skin infections (hot spots, abscesses)
- Gastrointestinal infections (parvovirus, giardiasis)
If your dog is displaying signs of illness, such as lethargy, loss of appetite, or fever, it’s crucial to consult your veterinarian promptly. They can determine if an infection is present and provide appropriate treatment.
2. Inflammatory Conditions

Chronic inflammatory diseases like arthritis, inflammatory bowel disease, or autoimmune disorders can also cause an increase in white blood cell counts.
Whenever the body experiences inflammation, it triggers a response that involves the production of more white blood cells to combat the perceived threat.
Examples of inflammatory conditions that may be associated with high white blood cell counts in dogs are:
- Osteoarthritis
- Inflammatory bowel disease (IBD)
- Autoimmune diseases (e.g., lupus, rheumatoid arthritis)
3. Leukemia
In some cases, a drastically elevated white blood cell count could signal something more serious – leukemia. This type of blood cancer results in the overproduction of abnormal white blood cells in the bone marrow, overwhelming the body’s ability to regulate cell production effectively.
Early detection is key, so if your vet suspects leukemia based on alarmingly high counts, further testing like a bone marrow aspiration may be recommended.
4. Certain Medications

It might surprise you to learn that some medications can actually cause an increase in white blood cell counts as a side effect. Corticosteroids, for instance, are known to stimulate the bone marrow to produce more of these cells, leading to leukocytosis.
If your dog is on any medications, make sure to follow your vet’s instructions carefully and monitor for any potential changes in their blood work.
5. Stress or Excitement

Your dog’s white blood cell count can spike slightly after a particularly stressful or exciting event. (ref) That’s because physiological stress triggers the release of hormones that temporarily boost white blood cell production.
While this short-term increase is usually harmless, chronic stress or anxiety can take a toll on your pup’s overall health and well-being, so it’s important to address any underlying causes.
6. Dehydration

Dehydration can lead to a relative increase in the concentration of white blood cells in the bloodstream. (ref) With lower fluid levels, the remaining blood volume contains a higher concentration of cells. Ensuring your dog has access to fresh, clean water and electrolyte-rich fluids can help restore their hydration levels and potentially normalize those white blood cell counts.
What Symptoms Should I Look Out For?

The symptoms associated with leukocytosis can vary depending on the underlying cause. Some common signs to watch out for include:
- Fever
- Lethargy
- Loss of appetite
- Weight loss
- Vomiting/Diarrhea
It’s important to note that these symptoms can be non-specific, and you may need to consult your veterinarian for a proper diagnosis.
Don’t hesitate to seek veterinary care if you have any concerns about your dog’s health or well-being. Early detection and treatment of leukocytosis and its underlying causes can significantly improve your dog’s prognosis and quality of life.
Source:
- https://www.msdvetmanual.com/dog-owners/blood-disorders-of-dogs/white-blood-cell-disorders-of-dogs
Davin is a jack-of-all-trades but has professional training and experience in various home and garden subjects. He leans on other experts when needed and edits and fact-checks all articles. Also an aspiring cook we he researches and tries all kinds of different food recipes and shares what works best.

